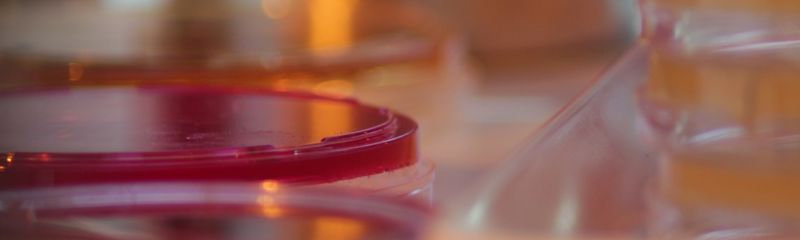
Fichier:Group-Le monde de l invisible Sans titre.png

Taille de cet aperçu : 800 × 240 pixels. Autre résolution : 960 × 288 pixels.
Fichier d’origine (960 × 288 pixels, taille du fichier : 253 Kio, type MIME : image/png)
Group-Le_monde_de_l_invisible_Sans_titre
Historique du fichier
Cliquer sur une date et heure pour voir le fichier tel qu'il était à ce moment-là.
| Date et heure | Vignette | Dimensions | Utilisateur | Commentaire | |
|---|---|---|---|---|---|
| actuel | 2 septembre 2020 à 15:22 | 960 × 288 (253 Kio) | Nathanaël Latour (discussion | contributions) | Group-Le_monde_de_l_invisible_Sans_titre |
- Vous ne pouvez pas remplacer ce fichier.
Utilisation du fichier
La page suivante utilise ce fichier :